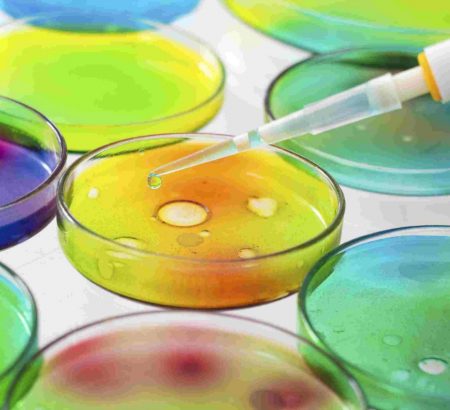

بیودایرکتوری و فروشگاه
Showing 1–20 of 78 resultsSorted by popularity
-
۱۹۹.۰۰۰تومان
-
۱۹۹.۰۰۰تومان
-
۱۹۹.۰۰۰تومان
-
۱۹۹.۰۰۰تومان
-
۱۹۹.۰۰۰تومان
-
۱۹۹.۰۰۰تومان
-
۱۹۹.۰۰۰تومان
-
۱۹۹.۰۰۰تومان
-
۱۹۹.۰۰۰تومان
-
۱۹۹.۰۰۰تومان
-
۱۹۹.۰۰۰تومان
-
۱۹۹.۰۰۰تومان
-
۱۹۹.۰۰۰تومان
-
۱۹۹.۰۰۰تومان
-
۱۹۹.۰۰۰تومان
-
۱۹۹.۰۰۰تومان